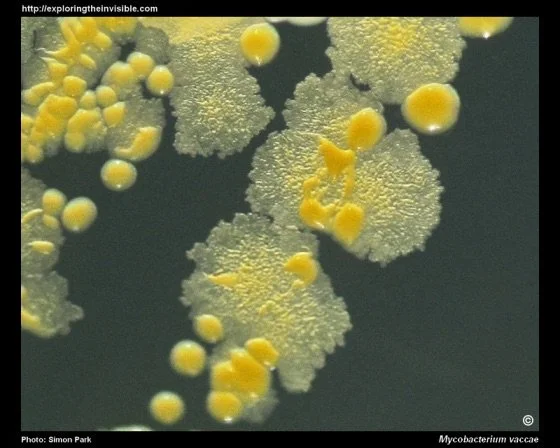
Diet Choices as Climate Action &amp; The effects of soil health on human health

Blog

When Improv, Trauma, and Neuroscience Collide: A Real-Life Lesson in Regulation
What happens when a fun improv class accidentally triggers a deep trauma response? I found myself shifting from excitement straight into a dorsal shutdown ("turtling up"). Instead of losing the night to doom-scrolling, I used a practical combination of IFS, Polyvagal theory, and somatic tools to map my way back to regulation. Read the full story and learn how you can apply these concrete nervous system tools to your own life and clinical practice.

Lithium orotate: the low-dose supplement that's turning heads in brain health research
I make a big distinction between what I do as a physician, one-on-one, with my patients, and what I think is safe for conversations between mental health practitioners and their clients. Here’s what a mental health professional should know when talking with their clients about lithium orotate.

Harvesting Resilience: What Failed Repetitions and Physiology Metrics Can Teach Us
Resilience is found through trying and stepping away from competence which is why the first thing that I try to get better at is caring for my body. It supports both my physical and mental health and take a ton of practice.

Meetup Group: Tacoma Nutrition and Healing Meetup Group
Meetup Mental Health Tool Kit. Third Wednesdays of each month at 6:30 pm PST.




Celebrating Dr. Sara Weelborg's Groundbreaking Research & New Mental Health Program!
I want to extend huge congratulations to Dr. Sara Weelborg, DNP, ARNP, PMHNP-BC, on two major accomplishments. First, on the publication of her doctoral paper, "A Quality Improvement Project to Promote Awareness and Knowledge of Nutrition as an Adjunctive Treatment Option for Chronic Insomnia."

Reflecting on 2024: Fueling Brains and Building Resilience
2024 was a year of growth and resilience for me. I navigated significant personal changes, including a broken hand, which forced me to prioritize self-care and truly embody the principles I teach. This experience reinforced the importance of focusing on the fundamentals: food, sleep, movement, breathing, and supportive connections.